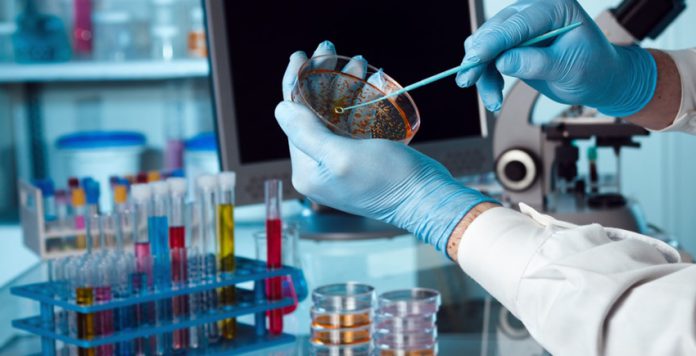
Work in the laboratory

What is a survey? Is this a concept that applies only to forensic medicine, or is the term used in other areas of life? If this concept is widely used, will the definition of the term, its meaning, be different for each individual sphere of life? There are many similar questions for those who are interested in the meaning and practical application of the word “survey”.
Generalized concept
Of course, every word that is a term has a common initial meaning. For example, when pronouncing “doctor”, each person will speak, representing a specialist in a particular area of life. However, the listener, who did not delve into the general context of the story, may well attribute the word to a completely different industry. But the general perception will still be true. Such words are called ambiguous terms.
It is to them that the "survey" refers. This is a combination of certain actions necessary for making an expert assessment of the state of an object, both technical and biological. These actions are carried out by specialists, and the results obtained during their implementation are documented. Professionals or experts with the right to conduct an examination should be empowered by the relevant authorities or possess a license. Without observing these formalities, an expert opinion will not have significant legal force. In other words, the assessment carried out by professionals who are not endowed with the appropriate authority will not be considered a survey, it will remain only a private opinion.
How can it be?
Based on the fact that the survey is a multi-valued term, we can assume that it is applicable to various spheres of life.
The concept can be:
- medical;
- technical;
- investigative.
Of course, each of these thematic areas includes narrower and specific survey options.
Medical Examination? What?
Like any other, a medical examination is a set of expert actions conducted to assess the condition. In this case, of course, man is the subject of research.
A medical examination, according to the definition, can be considered any assessment of the state of human health, documented and capable of entailing significant legal consequences.
What types of medical examinations are more common?
A medical examination of legal significance can concern almost any problem that arises in human health. In other words, you can examine the condition in accordance with the need.
But, of course, there are typical types of research. These include the following types:
- psychiatric
- to identify the state of intoxication;
- for contraindications to the implementation of any activity.
All types of examinations are carried out only in medical institutions, in accordance with the procedure established by law.
When is a psychiatric examination required?
Most people associate this type of examination with the need to establish sanity during the execution of guardianship or otherwise for other needs, and also associate with clarifying the state of mind at the time of any action.
Meanwhile, a psychiatric examination may be needed when applying for a job.Or for the implementation of a particular professional activity. For example, employees of enterprises who have constant contact with hazardous or poisonous, harmful substances undergo regular surveys.
The grounds for psychiatric examinations and the procedure for their implementation when applying for a job and directly in the course of labor activity are prescribed in the Labor Code of our country. That is, the mere desire of the employer to conduct a psychiatric examination of employees is not enough to carry out such an examination.
Such examinations are mandatory for people working:
- with hazardous or harmful substances, including pharmaceutical, chemical and biological components;
- with children or adolescents, both in educational institutions and in leisure centers;
- in the service sector, domestic homes, hotels, public places of rest;
- in power structures;
- at water intakes and sewage treatment plants, in other places related to urban facilities, including power plants.
This is a generalized list of areas of work, which require a document confirming the adequacy and absence of a number of nervous diseases.
What is a psychiatric examination?
Often people confuse this procedure with a routine examination. Meanwhile, these measures are completely different in their legal significance; they are not similar in terms of legislation.

As a rule, the passage of this examination by a person includes such moments:
- receiving directions from the employer describing the type of work activity;
- a commission visit at a local medical facility;
- waiting and receiving a documented result.
As a rule, the commission takes about a month. An inspection certificate may be issued into the hands or sent directly to the employer. Such a long waiting period is associated with the need to check a medical history. A person undergoing an expert examination may not have the necessary documents in his hands, for example, data on diseases transferred in childhood.
The procedure itself takes from thirty minutes to sixty and includes testing, surveys and other, similar methods of assessing mental activity, nervous state and level of thinking.
What is a drunkenness test?
As a rule, in everyday life, the detection of intoxication refers to the determination of the volume of alcohol drunk by a person. And also the establishment of the fact of its presence in the body. Meanwhile, a drunkenness test is a much broader concept, not related to alcohol.
The term includes the effects of drugs such as drugs, all kinds of toxins and other substances that cause human intoxication. Of course, alcohol also applies to them.
What is a drunkenness screening?
Most often, this procedure is encountered by car owners driving. Inspection of drivers is divided into primary and primary.

The primary procedure is understood as:
- visual inspection by an inspector;
- passing the breathalyzer;
- removal from control of the machine;
- delivery of a person or his independent arrival at a medical laboratory.
The primary stage is necessarily accompanied by the registration of the corresponding protocol. However, it does not have the same legal significance as a laboratory examination of a state of intoxication. This procedure includes an examination by a doctor and a collection of tests.
What is a survey for contraindications to work?
Not every profession can work people experiencing certain health difficulties.As a rule, the choice of work is limited for those who suffer from severe nervous or mental illnesses, such as epilepsy or schizophrenia. The reason for the refusal of employment can be and paroxysmal disorders.

In addition, in a number of professions, a restriction on access to work for people with:
- dependence on alcohol, drugs or other substances;
- developmental retardation and mental disability;
- various psychopathic or neurotic disorders;
- speech defects, including stuttering;
- tendency to sudden fainting.
In specific production or other sectors, more stringent restrictions have been adopted. The basis for refusing a person to be hired can only be a document confirming that he has health problems. In other words, even if, during an interview, a potential employer hears a stutter in a speech or becomes a witness to a swoon, without a medical opinion, he has no right to refuse a job for reasons related to health.
What is a technical survey?
This concept is closely related to technical diagnostics. In general, they are similar. But they have different legal meanings.

Technical examination - a combination of the actions of experts who are employees or representatives of government agencies. Their actions are aimed at giving an assessment of the current state of a particular object.
What areas do technical surveys apply to?
This type of survey is applicable in almost every area of human life. The subject of the examination can be absolutely any man-made object. For example, an inspection of the work is carried out upon delivery of the constructed building or after identifying any malfunctions.

In other words, an expert assessment is obligatory for those facilities where deficiencies, irregularities or malfunctions were discovered during special inspections. It is carried out after completion of work to eliminate them. A survey is also required for new facilities being put into operation.
What is an investigation examination?
The official name of this procedure is the criminal procedure examination. Like all other types of examinations, this includes a combination of actions of specialists conducted to assess the state of the subject of the examination.
In other words, this is nothing more than an investigative measure during which the absence or presence of signs of violence, damage, or other special signs on the human body is established.
This procedure can be carried out in order to identify any signs that are significant for the initiation or conduct of a criminal case.
What may be such an examination?
Investigative examination is divided into preliminary and judicial. The procedure for carrying out these procedures and the options for justifying them are listed in the Criminal Code of our country, in articles “179” and “290”.
Surveys conducted during the investigation are often confused with other procedures. Most often, primary examinations and forensic examinations of victims are taken as the investigative measure. The main key difference between this type of examination and others is that the assessment can be carried out before the initiation of the investigation and be the basis for its immediate start.

An investigative examination can be carried out not only in relation to victims or victims. An expert assessment may also be carried out with respect to the suspects or those who testify.